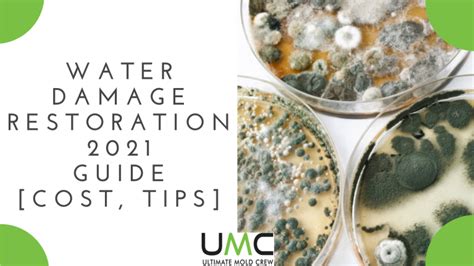

IOS Device Repair Services In Toronto: Your Ultimate Guide
iOS Device Repair Services in Toronto: Your Ultimate Guide
Hey tech enthusiasts! Toronto, a buzzing hub of innovation and a city that never sleeps, is also a place where your precious iOS devices – iPhones, iPads, and even iPods (remember those?) – are probably glued to your hands. But, let’s face it, accidents happen. That dreaded screen crack, the sudden battery drain, or the heart-stopping moment when your device takes an unexpected dip in the water. When these tech tragedies strike, you’re going to need a reliable iOS device repair service. This guide is your ultimate resource for navigating the landscape of iOS device repair services in Toronto , covering everything from what to look for in a repair shop to understanding common repair issues. So, grab a coffee, settle in, and let’s dive into the world of iPhone repair and beyond!
Table of Contents
- Decoding the iOS Device Repair Scene in Toronto
- Essential Services for iOS Devices
- Finding the Right iOS Device Repair Shop in Toronto
- Common iOS Device Repair Issues and Solutions
- DIY vs. Professional iOS Device Repair
- How to Prepare Your Device for Repair
- Data Privacy and Security During iOS Device Repair
- Conclusion: Keeping Your iOS Device Running Smoothly in Toronto
Decoding the iOS Device Repair Scene in Toronto
Alright, guys, let’s get the lay of the land. Toronto offers a plethora of options when it comes to iPhone repair and other iOS device repair services. You’ve got everything from big-box stores to smaller, independent repair shops. Each has its pros and cons, so choosing the right one can feel a bit overwhelming. But don’t sweat it! The key is to know what to look for and what questions to ask. First, think about the type of repair you need. Is it a simple screen replacement, a more complex battery issue, or something more serious, like water damage? This will help you narrow down your search. Next, consider the warranty . A reputable repair shop will always offer a warranty on their work. This shows they stand behind their services and are confident in the quality of their repairs. Warranty periods can vary, so make sure you understand the terms. Also, let’s not forget pricing . Get quotes from a few different shops before making a decision. Prices can vary significantly, so it’s a good idea to compare your options. But remember, the cheapest option isn’t always the best. Check online reviews . See what other customers are saying about the shop. Are they happy with the service? Are there any recurring complaints? Reviews are a goldmine of information! Finally, the expertise of the technicians is the most important factor. Make sure the shop has experienced technicians who are trained in iOS device repairs. Ask about their certifications and experience. When it comes to iOS device repair , you want someone who knows their stuff.
Essential Services for iOS Devices
Now, let’s talk about the specific services you’re likely to need. Screen repairs are, hands down, one of the most common issues. A cracked screen is practically a rite of passage for any iPhone owner, right? Fortunately, screen replacement is a relatively straightforward repair for experienced technicians. Next up, we have battery replacements. As your device ages, the battery’s performance degrades. You might notice your iPhone dying faster than usual, even with light usage. A battery replacement can breathe new life into your device, giving you more screen time and less charging anxiety. Water damage is another common culprit. This can be a major issue, so the sooner you can get it fixed, the better. Technicians will often use specialized equipment and techniques to try to save your device. Data recovery is a crucial service, especially if you haven’t backed up your data recently (pro tip: always back up your data!). If your device is damaged beyond repair, a skilled technician may be able to recover your precious photos, videos, contacts, and other important information. Software issues can also plague your iOS device. These can range from minor glitches to more serious problems, such as boot loops or operating system crashes. Repair shops can diagnose and fix these issues, restoring your device to its former glory. Finally, don’t overlook component-level repairs. This involves repairing individual components on the logic board, which can save you a lot of money compared to replacing the entire device. This type of repair requires advanced skills and specialized equipment, so make sure the shop you choose has the capability. Remember, choosing the right repair shop for your iOS device repair needs is crucial. Take your time, do your research, and don’t be afraid to ask questions. Your iPhone or iPad will thank you for it!
Finding the Right iOS Device Repair Shop in Toronto
Alright, you’re ready to find a repair shop, but where do you start? Toronto has tons of options, so here’s a roadmap to help you navigate the process. First off, start with online searches . Use search terms like “ iPhone repair Toronto ”, “ iPad repair Toronto ”, or “ iOS device repair near me ”. Google Maps is your friend here, showing you nearby shops and their customer reviews. Check online review platforms . Google Reviews, Yelp, and Facebook Reviews are all great resources for finding reliable repair shops. Pay attention to both the positive and negative reviews. This will give you a well-rounded understanding of the shop’s reputation. Ask for recommendations . Talk to your friends, family, and colleagues. They may have had positive experiences with repair shops in Toronto. Personal recommendations can be incredibly valuable. Once you have a shortlist of potential shops, check their websites . Look for information about their services, pricing, warranty, and experience. A professional website is a good sign that the shop is legitimate. Visit the shop in person . If possible, visit the shop before you need a repair. This will give you a feel for the environment and allow you to talk to the technicians. Observe how they interact with customers and how they handle devices. Check for certifications . While not always necessary, certifications from reputable organizations, such as CompTIA, can indicate that the technicians have a certain level of skill and knowledge. Inquire about the parts they use . Are they using genuine Apple parts, or third-party parts? Genuine parts are generally more reliable, but they may also be more expensive. Make sure you understand the difference and what you’re paying for. Ask about their turnaround time . How long will the repair take? This is especially important if you rely on your device for work or communication. Get a written estimate . Before you commit to the repair, get a written estimate that includes the price of the repair, the parts, and the warranty. This will help you avoid any surprises later on. By following these steps, you can find a reputable iOS device repair shop in Toronto that meets your needs and budget. Remember, choosing the right shop is an investment in your device’s longevity .
Common iOS Device Repair Issues and Solutions
Let’s dive into some common issues and how they’re typically addressed. First, let’s talk about screen damage. This is probably the most frequent issue. Whether it’s a cracked screen from a drop or a scratched screen from daily wear and tear, screen repair is a common need. The solution is usually a screen replacement, which is typically done quickly and efficiently by experienced technicians. Battery problems are another big one. As batteries age, they lose their ability to hold a charge. This results in shorter battery life and can be frustrating. A battery replacement will fix this, restoring your device to its original battery performance. Water damage is a serious issue that can cause a lot of problems. If your device gets wet, it’s essential to act fast. Turn it off immediately and take it to a repair shop. Technicians will often disassemble the device, clean it of any corrosion, and assess the damage to the internal components. The success of the repair depends on how quickly you act. Next up, we have software glitches . These can range from minor issues, such as apps crashing, to more serious problems, such as the device freezing or restarting randomly. The solution may involve software updates, restoring the device to factory settings, or even a complete system reinstall. Data recovery is a critical service for anyone who hasn’t backed up their device. If your device is damaged, a technician may be able to retrieve your photos, videos, contacts, and other important data. This is especially important if you have lost precious memories or important work files. Then, there are charging port problems . If your device won’t charge, the charging port may be damaged or clogged with debris. Technicians can clean or replace the charging port, restoring its ability to charge. Button malfunctions are a common problem. If the home button, power button, or volume buttons aren’t working properly, they can be replaced. This is a relatively simple repair that can restore your device’s functionality. Finally, speaker and microphone issues . If you can’t hear anything or can’t be heard during calls, the speakers or microphone may need to be replaced. These are just some of the most common iOS device repair issues. With the right repair shop, you can resolve most of these problems and keep your device running smoothly.
DIY vs. Professional iOS Device Repair
Alright, the age-old question: should you try to fix your device yourself, or should you take it to a professional? There are pros and cons to both approaches. DIY repair can save you money. If you’re tech-savvy and comfortable working with small electronics, you might be able to fix simple issues yourself, like a screen replacement. There are plenty of online tutorials available. DIY can also be satisfying. Knowing that you fixed your own device can be a great feeling. However, there are also significant risks. Repairing iOS devices requires specialized tools and skills. You could damage your device further, making the repair more costly or even impossible. You might also void your warranty, which means Apple won’t cover any future repairs. It can be time-consuming. DIY repairs can take hours, even days, especially if you’re not experienced. The risk of using the wrong parts is possible, leading to further issues. Professional repair offers several advantages. The biggest is expertise. Professional technicians have the training, experience, and tools to diagnose and fix a wide range of issues. They can also offer warranties, giving you peace of mind. Faster repair times are another advantage. Professionals can usually fix your device much faster than you can. They’ll also use high-quality parts, ensuring the repair is done correctly. The downside is that it can be more expensive. However, the cost is often worth it, especially if you want to avoid further damage to your device. In most cases, professional repair is the better option . It’s safer, more reliable, and can save you time and money in the long run. However, if you’re confident in your skills and you’re dealing with a minor issue, DIY might be worth a try. Just be sure to do your research and take precautions.
How to Prepare Your Device for Repair
Okay, your device needs to be repaired. Here’s how to get it ready for the process. Back up your data . This is the most crucial step. Back up your device before taking it in for repair. This ensures that you don’t lose any of your precious data, such as photos, videos, contacts, and documents. You can back up your device to iCloud or your computer using iTunes. Disable Find My iPhone/iPad . Find My iPhone/iPad is an important security feature, but it can sometimes complicate the repair process. Disable it before taking your device to the repair shop. Remove your SIM card . Remove your SIM card to protect your personal information and prevent accidental loss. Note any existing issues . Before taking your device to the shop, make a note of the issues you’re experiencing. This will help the technicians diagnose the problem more quickly. Provide your device’s passcode . Give the technicians your device’s passcode if necessary. This will allow them to test the device and verify that the repair has been successful. If you are concerned about your privacy, you can create a temporary passcode specifically for the repair. Gather your documentation . If your device is still under warranty, be sure to bring your proof of purchase or warranty documentation. Clean your device . Before taking your device in for repair, give it a quick cleaning. This will help the technicians to work on your device comfortably. Following these steps will help to ensure a smooth and successful repair experience. With a little preparation, you can get your device back in tip-top shape with minimal hassle.
Data Privacy and Security During iOS Device Repair
Data privacy and security are paramount when it comes to iOS device repair . You’re entrusting your personal information to the repair shop, so it’s essential to choose a shop that takes data security seriously. Choose a reputable shop . Look for shops with positive reviews and a strong track record of protecting customer data. Back up your data . As mentioned earlier, back up your data before taking your device in for repair. This is the best way to protect your data in case something goes wrong. Disable Find My iPhone/iPad . Disabling Find My iPhone/iPad can help protect your location data. Remove your SIM card . This will protect your phone number and any associated data. Set a passcode . Make sure your device has a strong passcode to prevent unauthorized access. You can also create a temporary passcode for the repair. Remove sensitive information . If possible, remove any sensitive information from your device before taking it in for repair. This could include photos, videos, and financial information. Ask about data security practices . Inquire about the shop’s data security practices. Do they have measures in place to protect your data? Do they offer data wiping services? Read the fine print . Review the shop’s privacy policy and terms of service before leaving your device for repair. Following these steps will help to protect your data and privacy during the repair process. Data security is important, so don’t be afraid to ask questions and take precautions. This will ensure your device is fixed without compromising your personal information.
Conclusion: Keeping Your iOS Device Running Smoothly in Toronto
There you have it! A comprehensive guide to iOS device repair services in Toronto . We’ve covered everything from finding the right repair shop to preparing your device for repair and protecting your data. Choosing the right repair shop is essential for keeping your device in good condition. Be sure to do your research, read reviews, and ask questions. With a little care and attention, you can keep your iPhone, iPad, or iPod running smoothly for years to come. Remember, accidents happen, but with the right resources and a reliable repair shop, you can get your device back up and running in no time. So, the next time your screen cracks or your battery starts to fail, you’ll know exactly what to do. Stay connected, Toronto, and keep enjoying your amazing iOS devices! Now go forth and conquer those tech troubles! And always remember, backing up your data is your best friend. Good luck, and happy repairing!